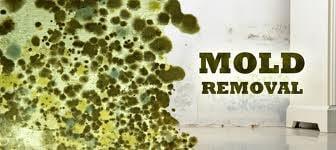
Dirty Deeds

ABM
2550 W Reno Ave Ste 106
Oklahoma City, OK 73107
Combining award-winning technology with more than 95 years of facility service cleaning experience, ABM Janitorial Services serves businesses and industries throughout the United States. Operating through an infrastructure of branch offices nationwide, ABM Janitorial merges national accessibility with the regional and local services its clients want, including blind cleaning, carpet care, document disposal, light industrial, food service sanitation, hard surface floor care, recycling services, pressure washing, supply management and upholstery cleaning. ABM s Fortune 1000 buying power offers savings to national accounts and local operations. The company is a subsidiary of ABM Industries. ABM Janitorial Services is located in cities such as Oklahoma City.
Also at this address
See a problem?
You might also like
Partial Data by Infogroup (c) 2025. All rights reserved.